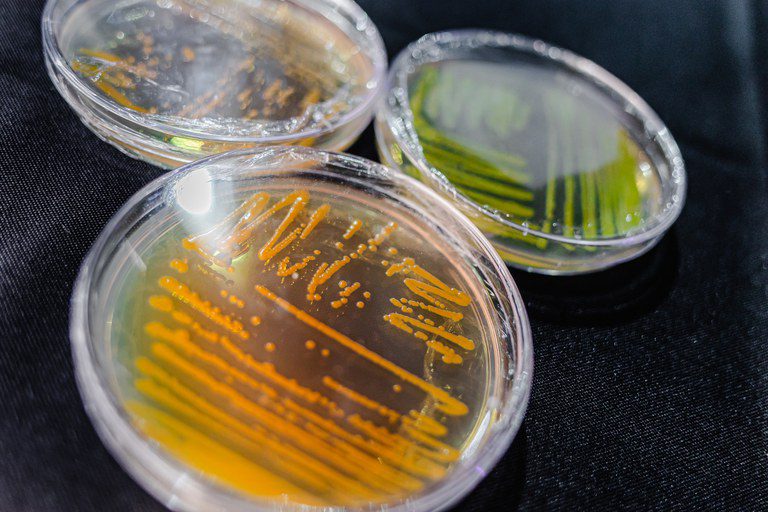
Bioplástico e inovação juvenil: ciência em ação nos estandes da Semana de Ciência e Tecnologia

Bioplástico e inovação juvenil: ciência em ação nos estandes da Semana de Ciência e Tecnologia
A combinação entre pesquisas avançadas e ações juvenis demonstra caminhos possíveis para enfrentar os desafios da poluição marinha
Enquanto o oceano enfrenta a pressão da poluição e a degradação de habitats, dois projetos brasileiros mostram caminhos práticos para proteção ambiental nos estandes da Semana Nacional de Ciência e Tecnologia 2025. Pesquisadores do Centro de Tecnologias Estratégicas do Nordeste (Cetene) transformam biopolímeros bacterianos em plásticos biodegradáveis e produzem mudas de manguezais para recuperar áreas degradadas, enquanto estudantes do Serviço Social da Indústria de Alagoas (Sesi Alagoas) criaram o Desin Craca, um solvente natural que remove cracas dos barcos de pescadores artesanais sem prejudicar o meio ambiente.
Microplásticos e biotecnologia
O Cetene , que é uma das 29 instituições vinculadas ao Ministério de Ciência, Tecnologia e Inovação (MCTI), faz o monitoramento ambiental em manguezais da Mata Atlântica, avaliando a contaminação por microplásticos em água, sedimentos, plantas e organismos aquáticos, como peixes, camarões e bivalves. A pesquisa também desenvolve bioplásticos biodegradáveis e técnicas de cultivo de mudas para restauração de áreas degradadas.
A pesquisadora do Cetene , Cândida Juliana, responsável pelo monitoramento e produção de mudas, explica a abrangência do trabalho: “Nós analisamos diversas matrizes ambientais — água, sedimento, plantas e todos os organismos aquáticos — e detectamos partículas de plástico em todos esses compartimentos. Nosso objetivo é mostrar como essas partículas afetam o ambiente, as plantas e os peixes”, afirmou.
Segundo a pesquisadora, a pesquisa alia biotecnologia à conservação ambiental, transformando poluentes em soluções sustentáveis. “Cultivamos bactérias capazes de produzir biopolímeros internamente, que transformamos em bioplástico biodegradável, oferecendo uma alternativa ao plástico derivado do petróleo que não se degrada”, explica.
Juventude transformando o litoral alagoano
Em Alagoas (AL), a equipe Séries Robo Câmbio, do Sesi local, desenvolveu o Desin Craca, um solvente natural e biodegradável que remove cracas dos barcos de pescadores artesanais, reduzindo esforço físico e riscos à saúde, especialmente para profissionais idosos. O produto combina bicarbonato de sódio, água oxigenada e vinagre, funciona em 20 minutos e pode ter resíduos descartados no lixo orgânico comum.
Mharia Eduarda Ferreira, de 15 anos, é uma das líderes da equipe e estudante do 1º ano no Sesi Alagoas, explica que é possível usar a ciência como um meio de cuidar da população. "Nossa região é totalmente litorânea e os pescadores têm dificuldade de trabalhar porque cracas grudam nos barcos. Desenvolvemos o Desin Craca para encontrar o equilíbrio entre ajudar o profissional e preservar o meio ambiente."
O projeto está em fase de testes em parceria com a Federação dos Pescadores do Estado de Alagoas, abrangendo seis regiões litorâneas: Ipioca, Maraial de Odore, São Miguel dos Milagres, Marcílio e Parieira . A equipe quer expandir o uso e, futuramente, comercializar a solução. Maria Eduarda detalha o impacto social: "Os pescadores artesanais são a base econômica de Alagoas, mas não têm visibilidade social ou governamental. A partir do projeto, eles garantem uma renda mais saudável e participam mais ativamente da comunidade”, afirmou Mharia .
Essas iniciativas mostram como ciência e tecnologia podem se unir à preservação ambiental e à melhoria da vida nas comunidades costeiras: enquanto uma pesquisa integra monitoramento de ecossistemas, biotecnologia e restauração ecológica, a outra aplica soluções práticas para desafios cotidianos do litoral.
A 22ª Semana Nacional de Ciência e Tecnologia segue até domingo (26). O evento é promovido pelo Ministério da Ciência, Tecnologia e Inovação, sob a coordenação da Secretaria de Ciência e Tecnologia para o Desenvolvimento Social (Sedes), e conta com o patrocínio de Financiadora de Estudos e Projetos (Finep); Huawei do Brasil Telecomunicações Ltda; Caixa Econômica Federal; Positivo Tecnologia S.A.; Conselho Federal dos Técnicos Industriais (CFT); Banco do Nordeste do Brasil S.A. (BNB); Conselho Federal de Química (CFQ); Agência Brasileira de Promoção Internacional do Turismo (Embratur); Comitê Gestor da Internet no Brasil / Núcleo de Informação e Coordenação do Ponto BR (CGI.br e NIC.br) e Associação das Indústrias Aeroespaciais do Brasil ( Aiab ).
A reprodução é gratuita desde que citada a fonte